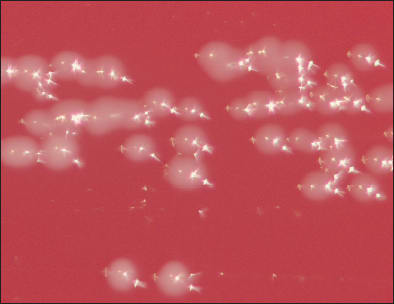

Case Study
Chronic Endophthalmitis Caused by Propionibacterium acnes: A Clinicopathologic Report
Andrew A. Kao, MD • Darlene Miller, DHsc • Sander R. Dubovy, MD • Harry W. Flynn, Jr., MD
Chronic or delayed-onset postoperative endophthalmitis is characterized by persistent low-grade inflammation, often with a latent onset worsening over months.3-6 Although estimated to be less common than acute-onset endophthalmitis, the true incidence of chronic endophthalmitis is still not known.5 In one single-center series, the reported rate of chronic postoperative endophthalmitis following cataract surgery was 0.017%.6
Propionibacterium acnes is an anaerobic, gram-positive pleomorphic bacillus found in the skin and hair follicles of normal individuals and is known to cause both acute-onset and delayed-onset postoperative endophthalmitis.2-5,7 We present a post–cataract surgery patient with chronic recurrent endophthalmitis and microbiologic confirmation and histopathologic correlation of P. acnes infection.
CASE REPORT
A 68-year-old woman underwent uncomplicated cataract surgery with placement of a posterior-chamber IOL in her left eye in September 2009. She presented two months later with mild reduction in vision and moderate anterior-chamber cells that responded to topical steroids. Upon tapering the steroids, the inflammation returned.
Four months after cataract surgery (January 2010), a pars plana vitrectomy was performed, and intravitreal vancomycin and ceftazidime were prescribed. Cultures were positive for vancomycin-sensitive Staphylococcus epidermidis and Corynebacterium species. Upon tapering postoperative topical steroids, the inflammation returned, but her visual acuity remained 20/25 in the left eye. She was referred to our center at this point for consultation. The differential diagnosis included infectious endophthalmitis caused by fungi or by P. acnes vs a lens-material–induced chronic inflammation. Moxifloxacin and prednisolone drops were continued.
She was observed for the next four months, when she presented in May 2010 with recurrent inflammation, pain and redness of the left eye. On examination, her visual acuity was 20/40, and slit-lamp examination disclosed multiple progressive keratic precipitates and a hypopyon (Figure 1). The antibiotics and steroids were increased, and the hypopyon resolved with a reduction in the inflammation. The medications were slowly tapered.

Figure 1. A slit-lamp photograph of the left eye demonstrates keratic precipitates (KPs) prior to pars plana vitrectomy. These KPs resolved after treatment.
In June 2010, she returned with a visual acuity of 20/30 OS, a recurrent hypopyon and 2+ vitreous cells. A pars plana vitrectomy with intraocular lens removal was performed and intravitreal injections of vancomycin and dexamethasone were given. Histologic examination of the specimen disclosed lens capsule, cortical lens material, lens epithelium, and metaplastic fibrocellular tissue, with a moderate amount of gram-positive coccobacilli present within the tissue (Figure 2a). Cultures of the capsular bag contents in a thioglycollate broth and on anaerobic blood agar were positive for P. acnes (Figure 2b).
At one month after treatment, the keratic precipitates resolved, and visual acuity improved. At the six-month follow-up (January 2011), the best-corrected visual acuity was 20/25 using an aphakic contact lens for the left eye.

Figure 2a. Propionibacterium acnes organisms within the capsular bag. Brown & Hopps Gram stain, 1000x magnification. Arrowheads = lens capsule, asterisk = P. acnes organisms.
Figure 2b. A photograph of an anaerobic blood agar plate demonstrates yellow-tan colonies typical of P. acnes growth.
DISCUSSION
The findings of chronic P. acnes endophthalmitis are often subtle, and these patients may lack the severe pain, poor vision and hypopyon often seen in acute-onset endophthalmitis.3,5,7 The classic clinical sign of P. acnes endophthalmitis is the presence of a white, creamy, intracapsular plaque that consists of peripheral lens cortex and sequestered organisms, as was noted in our patient.3-5,7 The inflammation may initially respond to topical steroids but often recurs with steroid tapering. Definitive diagnosis is achieved by Gram stain of the specimen and anaerobic cultures are necessary to confirm growth. Anaerobic cultures should be held for at least one to two weeks, as P. acnes is a slow-growing organism.1-5,7 Polymerase chain reaction may also be used to identify the organism in cases with negative smears and cultures.5,8
Initial treatment with intravitreal antibiotics may achieve transient improvement, but is associated with a high rate of recurrence.2-5,7 Curative treatment may involve vitrectomy and complete removal of the capsular bag and IOL removal or exchange.3,7 Resolution of KPs follows surgical treatment and is a clinical marker of infection resolution.9 The visual prognosis of chronic P. acnes endophthalmitis is generally more favorable than acute-onset postoperative endophthalmitis caused by more virulent organisms.1-2 RP
REFERENCES
1. Clark WL, Kaiser PK, Flynn HW Jr, Belfort A, Miller D, Meisler DM. Treatment strategies and visual acuity outcomes in chronic postoperative Propionibacterium acnes endophthalmitis. Ophthalmology. 1999;106:1665-1670.
2. Fox GM, Joondeph BC, Flynn HW Jr, Pflugfelder SC, Roussel TJ. Delayed-onset pseudophakic endophthalmitis. Am J Ophthalmol. 1991;111:163-173.
3. Aldave AJ, Stein JD, Deramo VA, Shah GK, Fischer DH, Maguire JI. Treatment strategies for postoperative Propionibacterium acnes endophthalmitis. Ophthalmology. 1999;106:2395-2401.
4. Roussel TJ, Culbertson WW, Jaffe NS. Chronic postoperative endophthalmitis associated with Propionibacterium acnes. Arch Ophthalmol. 1987;105:1199-1201.
5. Lemley CA, Han DP. Endophthalmitis: a review of current evaluation and management. Retina. 2007;27:662-680.
6. Al-Mezaine HS, Al-Assiri A, Al-Rajhi AA. Incidence, clinical features, causative organisms, and visual outcomes of delayed-onset pseudophakic endophthalmitis. Eur J Ophthalmol. 2009;19:804-811.
7. Mandelbaum S and Meisler DM. Postoperative chronic microbial endophthalmitis. Int Ophthalmol Clin. 1993;33:71-79.
8. Therese KL, Anand AR, Madhavan HN. Polymerase chain reaction in the diagnosis of bacterial endophthalmitis. Br J Ophthalmol. 1998;82:1078-1082.
9. Javey G, Albini TA, Flynn HW Jr. Resolution of pigmented keratic precipitates following treatment of pseudophakic endophthalmitis caused by Propionibacterium acnes. Ophthalmic Surg Lasers Imaging. 2010:1-3. doi: 10.3928/15428877-20100215-61. [Epub ahead of print]
| Andrew A. Kao, MD, is a preresident ocular pathology fellow at Bascom Palmer Eye Institute (BPEI). Darlene Miller, DHSc, is a research assistant professor and the scientific director of the Abrams Ocular Microbiology Laboratory at BPEI. Sander R. Dubovy, MD, is associate professor of ophthalmology and pathology and director of the Florida Lions Ocular Pathology Laboratory at BPEI. Harry W. Flynn, Jr., MD, is professor and J. Donald M. Gass Distinguished Chair of Ophthalmology at Bascom Palmer. The authors of this article have no financial or proprietary interests in products, methods or materials published in this manuscript. Dr. Flynn can be reached via e-mail at hflynn@med.miami.edu. |








